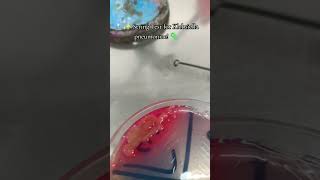

Microb World
Exploring the world of Microb world !🌎
Join me on microbiolgy adventure! 🔬🦠
Shared 1 month ago
29 views
Shared 1 year ago
38 views
Shared 1 year ago
61 views
Shared 1 year ago
86 views
Shared 1 year ago
63 views